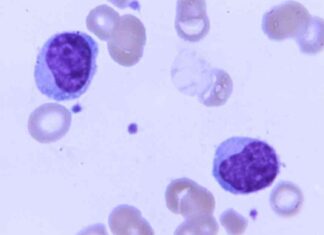
Kura Oncology Licenses Leukemia Drug to Japanese Drugmaker news-21112024-122547

Tag: Health
Analyze Trump’s Recent Health Appointments: What You Need to Know
President-elect Trump has recently made some key appointments in the health sector, including the FDA commissioner, CDC director, and surgeon general. These individuals have stirred up some controversy due to their backgrounds and previous...
Managing Ascites in Cancer Patients: Understanding Side Effects
Ascites is the abnormal buildup of fluid in the abdomen, causing swelling. It can be caused by certain types of cancer, especially advanced cancer that has spread to the peritoneal cavity. When cancer cells...
Mysterious Bird Flu Case in British Columbia: What We Know So Far
Health officials in British Columbia, Canada, have concluded their investigation into a mysterious case of a teenager being infected with H5N1 bird flu. The province's public health officer, Bonnie Henry, announced that the investigation...
Supporting Aging Loved Ones to Age in Place: Tips and Resources
As our loved ones age, they may prefer to stay in the comfort of their own homes, known as "aging in place." However, this may require some planning and support to ensure they can...
Former FDA Chief Seeks to Undermine RFK Jr.’s Senate Confirmation
Former FDA Chief Expresses Concerns Over RFK Jr.'s Senate ConfirmationIn a recent television appearance, Scott Gottlieb, the former commissioner of the Food and Drug Administration under the Trump administration, has raised red flags with...
Caregiving Resources and Tips from National Institute on Aging | NIH MedlinePlus
Being a caregiver or care partner is a significant responsibility that involves managing someone else's healthcare, daily tasks, financial decisions, and more. It can be overwhelming to navigate all of these responsibilities while also...
Moonshot Initiative to Combat Cervical Cancer in the Indo-Pacific: What’s Missing?
President Joe Biden and the leaders of Australia, India, and Japan recently introduced a new initiative called the Quad Cancer Moonshot Initiative. This initiative aims to combat cervical cancer in the Indo-Pacific region by...
Pediatrics: The Growing Backbone of Medicine – Why It’s Essential
Pediatrics is a vital field in medicine that focuses on the health and well-being of children. However, recent challenges have highlighted the growing concerns within the pediatric workforce. The RSV epidemic that hit pediatric...
Healing Spiritual Wounds: How to Overcome Spiritual Injury
As a doctor, Robert Klitzman knows that healthcare providers are well-prepared to address the physical needs of patients in hospitals, but may struggle with the emotional and spiritual challenges they face. This realization prompted...
Jim O’Neill Named HHS Deputy Secretary by Trump: Biotech Investor
President-elect Trump has selected biotech investor Jim O'Neill as the nominee for deputy secretary of the Health and Human Services department. If confirmed, O'Neill would be responsible for overseeing the day-to-day operations of various...
FAQs: Understanding IGAs in Animals
Intentional Genomic Alterations (IGAs) in animals refer to changes made to an animal's DNA using modern molecular technologies. These alterations can include targeted DNA sequence changes like insertions, substitutions, or deletions, among others. Common...
Kura Oncology Licenses Leukemia Drug to Japanese Drugmaker
Kura Oncology and the Japanese drugmaker Kyowa Kirin have joined forces in a global partnership to work on Kura’s new treatment for acute leukemia. The drug, ziftomenib, is currently in a late-stage clinical trial...